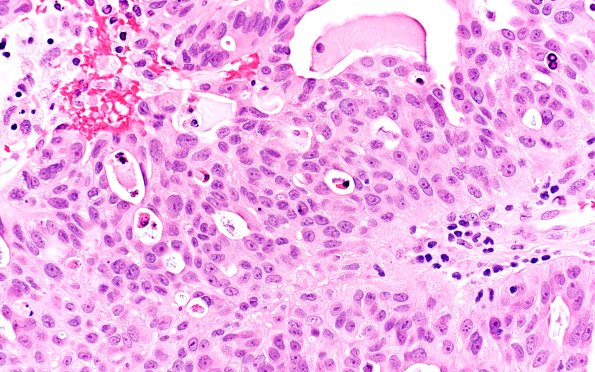
96A2 Metastasis, Lung adeno (Case 96) H&E 40X

Table of Contents
Washington University Experience | NEOPLASMS (METASTASES) | Microscopic | 96A2 Metastasis, Lung adeno (Case 96) H&E 40X
H&E-stained sections show a moderately differentiated metastatic adenocarcinoma with cribriform and glandular architecture.